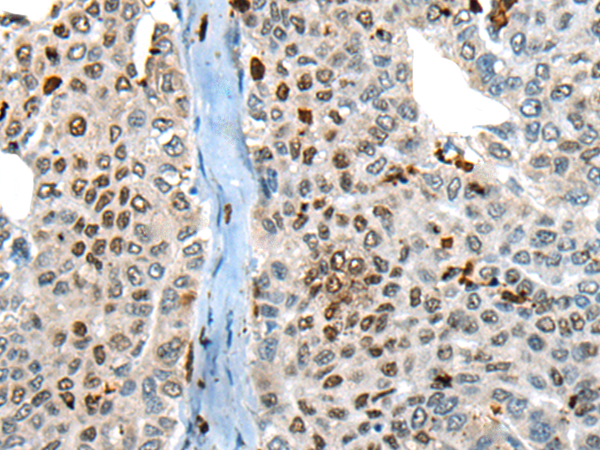
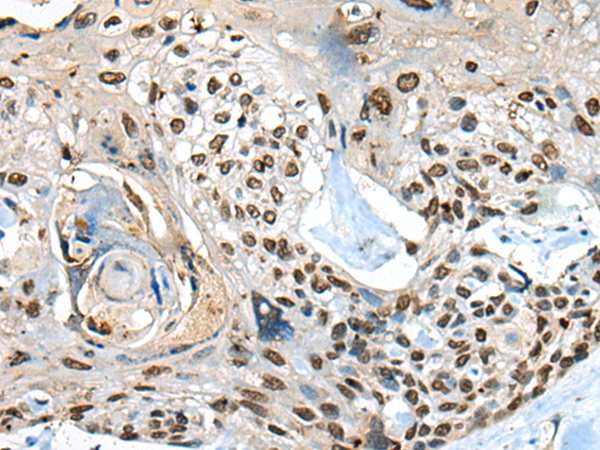
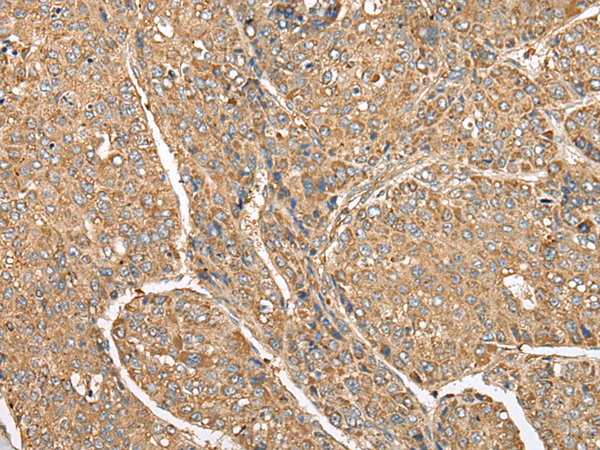

-
分类: 科研抗体货号: P09420别名: CABP3应用: IHC反应种属: Human, Mouse
-
分类: 科研抗体货号: P09419别名: CAVII应用: WB,IHC反应种属: Human, Mouse
-
分类: 科研抗体货号: P09440别名: PEBP2B应用: WB,IHC反应种属: Human, Mouse
-
分类: 科研抗体货号: P09417别名: C8orf72应用: IHC反应种属: Human, Mouse, Rat
-
分类: 科研抗体货号: P09462别名: APC8; CUT23; ANAPC8应用: WB,IHC反应种属: Human, Mouse
-
分类: 科研抗体货号: P09438别名: LL37; CAP18; CRAMP; HSD26; CAP-18; FALL39; FALL-39应用: IHC反应种属: Human
-
分类: 科研抗体货号: P09416别名:应用: WB反应种属: Human, Mouse
-
分类: 科研抗体货号: P09461别名: NYD-SP15; bA103J18.1应用: WB,IHC反应种属: Human, Mouse
-
分类: 科研抗体货号: P09437别名: DAPK应用: IHC反应种属: Human, Mouse
-
分类: 科研抗体货号: P09415别名: C5A; C5AR; C5R1; CD88应用: IHC反应种属: Human

鄂公网安备42018502007531号
鄂公网安备42018502007531号

